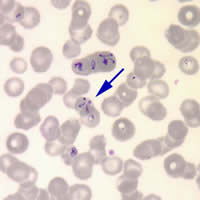

|
Answer
to Case 75
This was a case of babesiosis. The key microscopic diagnostic features
were:
- No morphological stages other than rings were observed in the blood
smears.
- Characteristic Maltese cross arrangement of the microorganism was
consistent with Babesia sp., a diagnostic feature that is not
always seen in stained blood smears (Figure A).
- Absence of pigment in the infected red blood cells.
|
A |
|
|